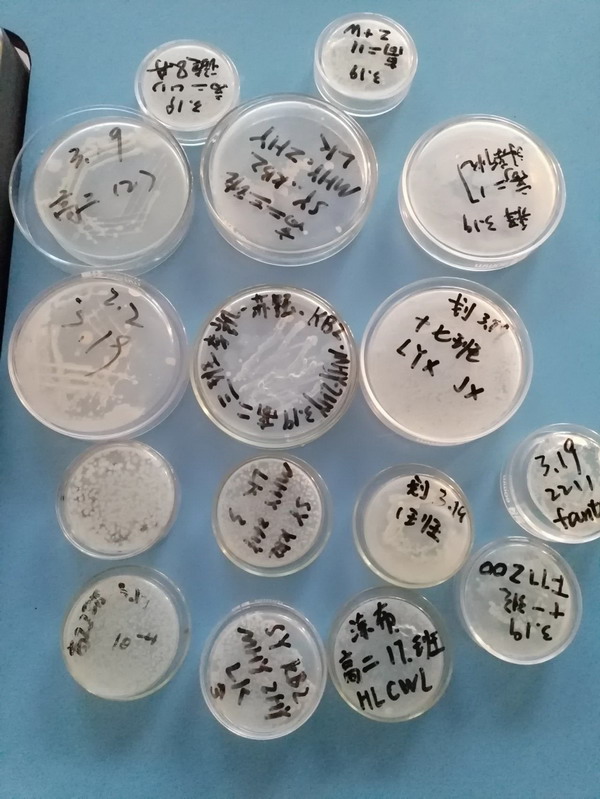
9_缩小大小.jpg

——包头四中生物实验课
生物来源于生活,应用于生活,它从来都不只是存在于书本上的理论,也并不是遥不可及。为了让同学们更深入理解微生物的意义,认识到微生物的无处不在,加深对书本理论知识的理解,我校高二生物组将传统发酵技术和微生物培养带入实验课堂,让学生们自己动手,亲自感受果酒、果酒酿制和泡菜腌制的中国传统美食文化魅力,学习与实践相结合,在做中学,在学中悟。
“发酵”是人们利用微生物生产有用代谢产物的一种生产方式,在中国有着数千年的历史,是中国劳动人民生活智慧的结晶。约9000年前,我们的祖先就会利用微生物将谷物、水果等发酵为含酒精的饮料。后来,人们通过自然发酵或菌种传代的固体发酵方法生产其他食品,如泡菜、腐乳、米酒和酱油等。这种传统发酵技术促进了中华民族特有的、丰富多彩的饮食文化的形成。

同学们自备容器,共同制作了泡菜,果酒,过了一把“发酵”的瘾!发酵的前提是微生物的培养,同学们在另一次的实验课中完成了固体培养基的制备,倒平板,稀释涂布平板和平板划线等等操作,做好标记,以便培养几天后观察菌落生长情况。很多生物实验的周期比较长,我们的实验室一直开放的,学生可以随时来观察自己的实验进展情况。

纸上得来终觉浅,觉知此事要躬行,本次传统发酵食品的制作和微生物培养活动,真正做到将学科知识运用到生活实践中,让学生切实感受到了“生物学从生活中来并服务于生活”的理念,开拓了学生的视野,提升了学生的动手能力,培养了学生的科学思维,体现并落实了“教学过程重实践”的生物新课程理念。
供稿|高二年级生物组
教研处
一审|宋献红
王丽俊
二审|边永亮
三审|张雪峰
评论
还能输入140字
用户评论
经过核实,本空间由于存在敏感词或非法违规信息或不安全代码或被其他用户举报,
已被管理员(或客服)锁定。
本空间现无法正常访问,也无法进行任何操作。
如需解锁请联系当地教育技术部门,由当地教育技术部门联系锁定人处理。
当前机构空间已被管理员(或客服)封锁。
目前机构空间无法正常访问,也无法进行任何操作。
如需重新开放,请联系当地教育技术部门,由当地教育技术部门联系管理员(或客服)处理。